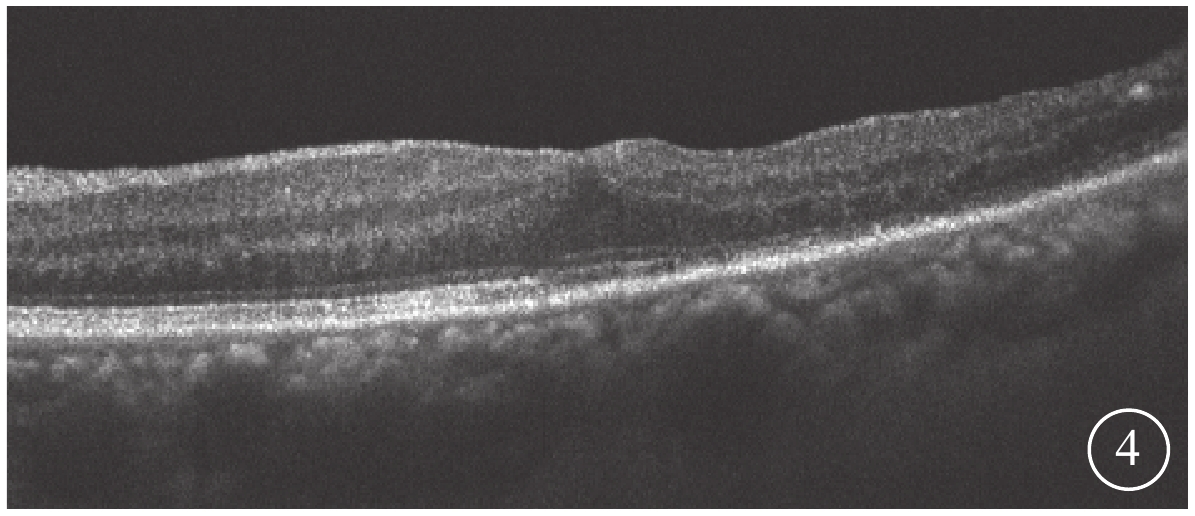

引用本文: 張軍, 程湧, 梁建宏, 黎曉新. 25G玻璃體切割手術治療視網膜大動脈瘤內界膜下出血三例. 中華眼底病雜志, 2017, 33(4): 409-410. doi: 10.3760/cma.j.issn.1005-1015.2017.04.020 復制
視網膜大動脈瘤(RAM)是獲得性視網膜中央動脈的分支血管發生擴張,病變最常發生于視網膜動脈3級分支以內,典型者位于黃斑或后極部[1, 2]。RAM可分為靜止型、滲出型和出血型;出血型RAM又細分為玻璃體內積血、玻璃體后界膜下出血、內界膜下出血、視網膜內出血和視網膜下出血[3]。內界膜下出血及玻璃體后界膜下出血的吸收過程可能長達數月,濃厚的出血可致視網膜前膜形成并對視網膜產生不可逆性損害,因此施行玻璃體切割手術清除積血對于保護視網膜功能是有益的[4]。我們采用25G玻璃體切割手術聯合內界膜剝除及激光光凝對RAM致內界膜下出血的3例患者進行了治療,對其有效性、安全性進行了臨床觀察,現將結果報道如下。
1 對象和方法
回顧性研究。2016年4~7月在北京大學人民醫院眼科確診為RAM所致黃斑區內界膜下出血的3例患者3只眼納入本研究。其中,男性1例1只眼,女性2例2只眼。年齡62~75歲,平均年齡為(69.0±6.5)歲。病程1~8個月,平均病程(5.0±3.6)個月。均為單眼發病,左眼2只,右眼1只。均主訴突然視力下降伴中心黑影遮擋。3例患者均有高血壓病史。其中1例患者曾于2016年5月行左眼玻璃體腔注射雷珠單抗0.05 mg治療,但視力無明顯提高。
3只眼均行常規全身檢查及最佳矯正視力(BCVA)、眼壓、裂隙燈顯微鏡、眼底彩色照相、眼部B型超聲、熒光素眼底血管造影(FFA)及光相干斷層掃描(OCT)等眼部檢查。患眼BCVA為手動/20 cm~0.06,平均BCVA為0.03±0.02。眼壓為7.9~18.9 mmHg(1 mmHg=0.133 kPa),平均眼壓為(9.87±3.23)mmHg。3只眼均存在不同程度的晶狀體混濁。RAM位于視網膜顳上2只眼,位于視網膜顳下1只眼。黃斑區內界膜下出血大小為1.5~8.0倍視盤面積。FFA檢查發現,動脈期患眼顳下視網膜動脈分支處強熒光點,周圍出血遮蔽視網膜及脈絡膜熒光(圖1)。OCT檢查發現,患眼出血灶表面可見一弧形強反射條帶,且與內界膜相對應,其下呈點狀強反射(圖2)。
 圖1
患眼FFA像。動脈期視網膜顳下可見強熒光點(白箭),上方出血遮蔽熒光
圖1
患眼FFA像。動脈期視網膜顳下可見強熒光點(白箭),上方出血遮蔽熒光
 圖2
圖1同眼OCT像。黃斑視網膜內層強反射
圖2
圖1同眼OCT像。黃斑視網膜內層強反射
3只眼均行玻璃體切割聯合內界膜剝除及激光光凝治療。球后麻醉后,于上方角膜緣后0.5 mm做隧道切口,超聲乳化吸除晶狀體,黏彈劑維持前房。左眼于5點、2點、10點時鐘位,右眼于7點、2點、10點時鐘位角膜緣后3.5 mm 25G鞏膜穿刺刀常規行經睫狀體平坦部鞏膜三切口,切除中央玻璃體。玻璃體切割頭于視盤前行人工玻璃體后脫離,曲安奈德染色,清除玻璃體后皮質,0.1%吲哚青綠內界膜染色1 min,25G內界膜鑷剝除約1.0~1.5個視盤直徑(DD)的內界膜。笛針吹吸內界膜下血凝塊。532 nm激光直接光凝瘤體,光斑大小200 μm,曝光時間0.3 s,能量150~250 mW,光凝點數2~3個,以瘤體呈淡灰白色即可。囊袋內植入人工晶狀體,氣液交換,玻璃體腔內注入16%C2F6至指測眼壓正常。手術完成后依次拔出套管及灌注頭,用棉簽輕輕按壓穿刺口,切口密閉良好。囑患者手術后俯臥位2周。
手術后隨訪時間1.5~3.0個月,平均隨訪時間(2.2±0.8)個月。隨訪觀察患眼手術后BCVA、FFA及OCT的變化情況。
2 結果
末次隨訪時,患眼BCVA為0.15~0.6,平均BCVA為0.42±0.24。患眼后房型人工晶狀體位正,黃斑部出血吸收。FFA檢查發現,患眼顳下視網膜動脈分支處強熒光點消失(圖3)。OCT檢查發現,患眼黃斑結構逐漸恢復(圖4)。所有患眼均未發生視網膜脫離、黃斑裂孔等并發癥。
 圖3
圖1同眼手術后FFA像。顳下視網膜動脈分支處強熒光點消失
圖3
圖1同眼手術后FFA像。顳下視網膜動脈分支處強熒光點消失
 圖4
圖1同眼手術后OCT像。黃斑中心凹形態恢復
圖4
圖1同眼手術后OCT像。黃斑中心凹形態恢復
3 討論
3只患眼經FFA檢查均可見動脈期顳側視網膜動脈分支處強熒光點,周圍出血遮蔽視網膜及脈絡膜熒光;OCT檢查可見出血灶表面一弧形強反射條帶,且與內界膜相對應,其下呈點狀強反射。證明其RAM及內界膜下出血診斷成立[5]。
因為3只患眼均存在不同程度的晶狀體混濁,且為防止玻璃體腔填充氣體后所致晶狀體混濁加重而影響視力恢復,我們于玻璃體切割手術中聯合白內障超聲乳化、人工晶狀體植入手術。內界膜染色后,于內界膜下出血部位并沿著RAM周圍剝除約1.0~1.5 DD的內界膜。剝除適當范圍的內界膜不僅使積血易于排出,而且可防止黃斑發生皺褶,并減少增生性玻璃體視網膜病變的發生幾率;但大范圍的內界膜剝除不僅無助于促進病變修復,且有導致發生視網膜裂孔的風險[6]。
激光光凝RAM可引起玻璃體視網膜出血、激光誘導性視網膜損害、視網膜前膜形成、因視網膜小動脈栓塞所致的黃斑梗死、硬性滲出加重、黃斑下視網膜瘢痕形成[7]。我們用笛針吹吸內界膜下積血及血凝塊后,采用532 nm眼內激光直接光凝瘤體,以瘤體呈淡灰白色即可。本組3只患眼未發生上述并發癥。說明低能量、較長曝光時間、較大光斑直接光凝瘤體至光斑反應呈2級較為安全。
手術即將結束時我們給予患眼玻璃體腔填充16%C2F6,因為沒有膨脹性,手術后眼壓保持良好。玻璃體腔氣體填充既能維持良好的眼壓又能減少病變區的再出血,同時可促進視網膜色素上皮泵功能的恢復。3只眼手術后BCVA均較手術前提高,且手術后無視網膜脫離、黃斑裂孔等并發癥發生。
本研究結果表明,玻璃體切割聯合內界膜剝除能迅速排出內界膜下出血,提高患眼視力,降低積血所致的視網膜不可逆性損害的風險,是治療RAM所致內界膜下出血的可選方法之一。但由于本研究為回顧性研究,存在樣本量小、非隨機對照、隨訪時間較短等不足,其結果有待更大樣本、更長隨訪時間的隨機對照研究加以驗證。
視網膜大動脈瘤(RAM)是獲得性視網膜中央動脈的分支血管發生擴張,病變最常發生于視網膜動脈3級分支以內,典型者位于黃斑或后極部[1, 2]。RAM可分為靜止型、滲出型和出血型;出血型RAM又細分為玻璃體內積血、玻璃體后界膜下出血、內界膜下出血、視網膜內出血和視網膜下出血[3]。內界膜下出血及玻璃體后界膜下出血的吸收過程可能長達數月,濃厚的出血可致視網膜前膜形成并對視網膜產生不可逆性損害,因此施行玻璃體切割手術清除積血對于保護視網膜功能是有益的[4]。我們采用25G玻璃體切割手術聯合內界膜剝除及激光光凝對RAM致內界膜下出血的3例患者進行了治療,對其有效性、安全性進行了臨床觀察,現將結果報道如下。
1 對象和方法
回顧性研究。2016年4~7月在北京大學人民醫院眼科確診為RAM所致黃斑區內界膜下出血的3例患者3只眼納入本研究。其中,男性1例1只眼,女性2例2只眼。年齡62~75歲,平均年齡為(69.0±6.5)歲。病程1~8個月,平均病程(5.0±3.6)個月。均為單眼發病,左眼2只,右眼1只。均主訴突然視力下降伴中心黑影遮擋。3例患者均有高血壓病史。其中1例患者曾于2016年5月行左眼玻璃體腔注射雷珠單抗0.05 mg治療,但視力無明顯提高。
3只眼均行常規全身檢查及最佳矯正視力(BCVA)、眼壓、裂隙燈顯微鏡、眼底彩色照相、眼部B型超聲、熒光素眼底血管造影(FFA)及光相干斷層掃描(OCT)等眼部檢查。患眼BCVA為手動/20 cm~0.06,平均BCVA為0.03±0.02。眼壓為7.9~18.9 mmHg(1 mmHg=0.133 kPa),平均眼壓為(9.87±3.23)mmHg。3只眼均存在不同程度的晶狀體混濁。RAM位于視網膜顳上2只眼,位于視網膜顳下1只眼。黃斑區內界膜下出血大小為1.5~8.0倍視盤面積。FFA檢查發現,動脈期患眼顳下視網膜動脈分支處強熒光點,周圍出血遮蔽視網膜及脈絡膜熒光(圖1)。OCT檢查發現,患眼出血灶表面可見一弧形強反射條帶,且與內界膜相對應,其下呈點狀強反射(圖2)。
 圖1
患眼FFA像。動脈期視網膜顳下可見強熒光點(白箭),上方出血遮蔽熒光
圖1
患眼FFA像。動脈期視網膜顳下可見強熒光點(白箭),上方出血遮蔽熒光
 圖2
圖1同眼OCT像。黃斑視網膜內層強反射
圖2
圖1同眼OCT像。黃斑視網膜內層強反射
3只眼均行玻璃體切割聯合內界膜剝除及激光光凝治療。球后麻醉后,于上方角膜緣后0.5 mm做隧道切口,超聲乳化吸除晶狀體,黏彈劑維持前房。左眼于5點、2點、10點時鐘位,右眼于7點、2點、10點時鐘位角膜緣后3.5 mm 25G鞏膜穿刺刀常規行經睫狀體平坦部鞏膜三切口,切除中央玻璃體。玻璃體切割頭于視盤前行人工玻璃體后脫離,曲安奈德染色,清除玻璃體后皮質,0.1%吲哚青綠內界膜染色1 min,25G內界膜鑷剝除約1.0~1.5個視盤直徑(DD)的內界膜。笛針吹吸內界膜下血凝塊。532 nm激光直接光凝瘤體,光斑大小200 μm,曝光時間0.3 s,能量150~250 mW,光凝點數2~3個,以瘤體呈淡灰白色即可。囊袋內植入人工晶狀體,氣液交換,玻璃體腔內注入16%C2F6至指測眼壓正常。手術完成后依次拔出套管及灌注頭,用棉簽輕輕按壓穿刺口,切口密閉良好。囑患者手術后俯臥位2周。
手術后隨訪時間1.5~3.0個月,平均隨訪時間(2.2±0.8)個月。隨訪觀察患眼手術后BCVA、FFA及OCT的變化情況。
2 結果
末次隨訪時,患眼BCVA為0.15~0.6,平均BCVA為0.42±0.24。患眼后房型人工晶狀體位正,黃斑部出血吸收。FFA檢查發現,患眼顳下視網膜動脈分支處強熒光點消失(圖3)。OCT檢查發現,患眼黃斑結構逐漸恢復(圖4)。所有患眼均未發生視網膜脫離、黃斑裂孔等并發癥。
 圖3
圖1同眼手術后FFA像。顳下視網膜動脈分支處強熒光點消失
圖3
圖1同眼手術后FFA像。顳下視網膜動脈分支處強熒光點消失
 圖4
圖1同眼手術后OCT像。黃斑中心凹形態恢復
圖4
圖1同眼手術后OCT像。黃斑中心凹形態恢復
3 討論
3只患眼經FFA檢查均可見動脈期顳側視網膜動脈分支處強熒光點,周圍出血遮蔽視網膜及脈絡膜熒光;OCT檢查可見出血灶表面一弧形強反射條帶,且與內界膜相對應,其下呈點狀強反射。證明其RAM及內界膜下出血診斷成立[5]。
因為3只患眼均存在不同程度的晶狀體混濁,且為防止玻璃體腔填充氣體后所致晶狀體混濁加重而影響視力恢復,我們于玻璃體切割手術中聯合白內障超聲乳化、人工晶狀體植入手術。內界膜染色后,于內界膜下出血部位并沿著RAM周圍剝除約1.0~1.5 DD的內界膜。剝除適當范圍的內界膜不僅使積血易于排出,而且可防止黃斑發生皺褶,并減少增生性玻璃體視網膜病變的發生幾率;但大范圍的內界膜剝除不僅無助于促進病變修復,且有導致發生視網膜裂孔的風險[6]。
激光光凝RAM可引起玻璃體視網膜出血、激光誘導性視網膜損害、視網膜前膜形成、因視網膜小動脈栓塞所致的黃斑梗死、硬性滲出加重、黃斑下視網膜瘢痕形成[7]。我們用笛針吹吸內界膜下積血及血凝塊后,采用532 nm眼內激光直接光凝瘤體,以瘤體呈淡灰白色即可。本組3只患眼未發生上述并發癥。說明低能量、較長曝光時間、較大光斑直接光凝瘤體至光斑反應呈2級較為安全。
手術即將結束時我們給予患眼玻璃體腔填充16%C2F6,因為沒有膨脹性,手術后眼壓保持良好。玻璃體腔氣體填充既能維持良好的眼壓又能減少病變區的再出血,同時可促進視網膜色素上皮泵功能的恢復。3只眼手術后BCVA均較手術前提高,且手術后無視網膜脫離、黃斑裂孔等并發癥發生。
本研究結果表明,玻璃體切割聯合內界膜剝除能迅速排出內界膜下出血,提高患眼視力,降低積血所致的視網膜不可逆性損害的風險,是治療RAM所致內界膜下出血的可選方法之一。但由于本研究為回顧性研究,存在樣本量小、非隨機對照、隨訪時間較短等不足,其結果有待更大樣本、更長隨訪時間的隨機對照研究加以驗證。